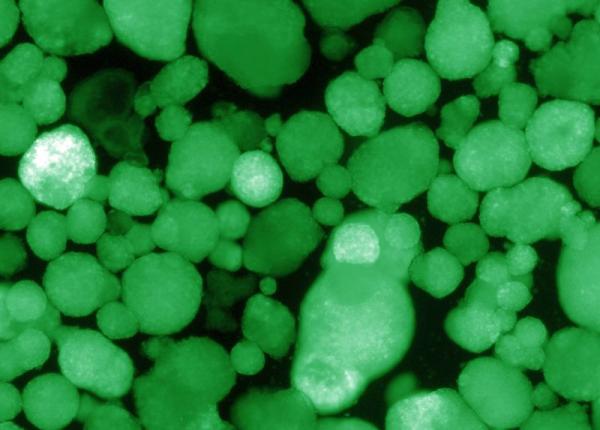
diabetul de tip 1 la un pas de a fi vindecat descoperire epocala

Articole publicate de Dana Lascu
Emil Jula a făcut infarct, la doar 40 de ani. Simptomele care prevestesc fatalul accident
Dr Otilia Țigănaș, medic de familie: „Măcar aveți la cine zbiera”. Pericolul triajului în poarta școlii
Recomandări noi de la OMS pentru copii: care dintre ei ar trebui să poarte mască
GCS, bilanț COVID-19: Număr record de persoane internate la ATI, în 22 august
Dr Mihai Craiu: Cum ne putem îmbolnăvi de COVID-19 într-o școală din România - scurt îndreptar bazat pe dovezi!
Vestea-BOMBĂ de la OMS: Cât ar putea dura pandemia COVID-19
Dr Imbri: „Se vor redeschide școlile și mi-e frică”. Grupele de vârstă în cel mai MARE PERICOL
EXCLUSIV Lacrimile artificiale PERICULOASE. De ce îți provoacă iritația ochilor. EXCLUSIV
Fetiță de 3 ani, internată în stare gravă cu COVID-19. Avea rude venite din Italia
Broccoli și varza de Bruxelles, fantastice pentru femei. Studiu, bolile FATALE de care te feresc
Dr Monica Pop, AVERTISMENT: O strategie greșită, se vor trezi infectați! Dar, dacă așa e ordinul...
Dr Monica Pop spune că autoritățile au o strategie greșită care duce, de fapt, la creșterea numărului de infectați.
EXCLUSIV Oana Roman, confesiunile unei vedete la Interviurile DC Medical. Despre depresie și dietă
EXCLUSIV Operație bariatrică cu robotul daVinci. Pacient cu obezitate morbidă, fără cicatrici uriașe de la operație
EXCLUSIV Robotul cu care un chirurg te operează de pe partea cealaltă a Pământului. EXPLICAȚII VIDEO
EXCLUSIV Chirurgia robotică, cu ce e mai bună față de cea laparoscopică. Despre avantaje, cu dr Bogdan Marțian
EXCLUSIV Dr Bogdan Marțian: avantaje uriașe pentru pacienți, prin chirurgia minim-invazivă. „Se întorc mai repede la job”
EXCLUSIV Știrile amiezii - 20 august. Cele mai recente informații din SĂNĂTATE
DC Medical vă prezintă cele mai recente știri din sănătate ale zilei de 20 august.
EXCLUSIV Dr Bogdan Marțian: Primele intervenții de chirurgie robotică la Sanador. Interviurile DC News și DC Medical
Nou caz de CORONAVIRUS la Ministerul Sănătății. Al 5-lea de luna asta
Socializare în PANDEMIE: 5 întrebări pe care să ți le pui ÎNAINTE să te întâlnești cu prietenii
Anemie, de ce apare și cum ne vindecăm. Alimente pe care trebuie să le mâncăm
3 motive ca să previi sau să controlezi hipertensiunea, în afară de infarct și AVC. Este „ucigașul tăcut”
Petrecere ilegală oprită de Poliție. I-au prins cu camerele cu termoviziune
Diabetul de tip 1, la un pas de a fi vindecat? Descoperire EPOCALĂ
Oamenii de știință au făcut un un pas major spre obținerea unui tratament sigur și eficient pentru diabetul de tip 1.
Cearcănele, ce sunt și ce boli pot ascunde
Premierul australian s-a sucit: Vaccinarea pentru COVID-19 va fi „încurajată”, nu „obligatorie”
Risc URIAȘ pentru vegani. Dr Simona Carniciu, alimentele la care NU trebuie să renunți
Dr Simona Carniciu a explicat că veganii se expun unui risc uriaș de a face mai multe boli, atunci când renunță la anumite alimente.
Profesorul Klaus Iohannis, ce ar face dacă un elev de-al său ar avea febră. Ce a răspuns
Dr Virgil Musta, an școlar 2020 - 2021: Cum poate începe școala în pandemie. 13 reguli de urmat
An școlar 2020-2021. Medic de familie: Am fost obișnuiți să păcălim! Nu avem cultura prevenirii transmiterii bolilor infecțioase
EXCLUSIV Sindromul ochiului uscat, ce este și care sunt simptomele
EXCLUSIV Știrile amiezii - 19 august. Cele mai recente informații din SĂNĂTATE
DC Medical vă prezintă cele mai recente știri din sănătate ale zilei de 19 august.
EXCLUSIV Legea care face mâncarea românilor mai SĂNĂTOASĂ. Adrian Wiener: Nu interzice alimente! Oprește un ABUZ criminal URIAȘ!
Prof dr Ioan Sîrbu, culisele GCS. Propunere pentru Orban: „Cifre pentru care nu semnează nimeni”
8 alimente care scad colesterolul „rău” LDL
Anumite alimente pot alcătui o dietă care să scadă colesterolul. Iată câteva dintre ele:
Nadia Comăneci și-a făcut deja vaccinul contra gripei! Anunțul făcut de marea gimnastă
Nadia Comăneci, legenda gimnasticii mondiale, prima sportivă care a luat nota 10 la Olimpiadă, a făcut anunțul pe Instagram.
Educația pozitivă sau cum să creștem copiii fericiți, explicațiile psihologului
Psihologul Laura Maria Cojocaru explică ce înseamnă educația pozitivă și cum se pune ea în aplicare.
Ioan Sîrbu, atac la medici și la Guvern: Asta e cea mai mare greșeală medicală din pandemie!
Faimosul compozitor Andrew Lloyd Webber, voluntar în studiul pentru vaccinul anti-COVID de la Oxford
An școlar 2020 – 2021. Ana Măiță: Dacă aș fi ministru acum, nu aș putea să dorm noaptea. Cea mai bună soluție
Avertisment OMS, coronavirus: „Epidemia se schimbă!” O mutație de 10 ori mai infecțioasă
5 alimente care-ți scad drastic riscul de demență
Un studiu recent arată că cinci alimente, consumate în cantități mari, sunt legate de un risc scăzut cu aproape 40% de a face demență.
Orzul, colecție de fibre, vitamine și minerale. Bolile fatale de care te ferește
Medicii de familie: cum trebuie să înceapă noul an școlar, în contextul pandemiei de SARS CoV-2
De ce n-am scăpat de focarele de COVID-19 în vara asta. Transmitere comunitară
Rusia va testa vaccinul chinez anti-coronavirus. Sute de voluntari deja înscriși
China își va testa în Rusia vaccinul anti-coronavirus pe care l-a patentat deja. Acesta se află în a treia fază a studiilor clinice.
8 alimente care te îmbătrânesc mai repede
Descoperire ALARMANTĂ la autopsii: Microplastic în ORGANELE UMANE!
Particule mici de plastic se găsesc și se acumulează în toate organele majore din corpul nostru, arată un nou studiu.
China are vaccin patentat pentru COVID-19. L-a testat pe soldați!
China a patentat propriul vaccin pentru COVID-19 și a anunțat că este gata să treacă la producția în masă.